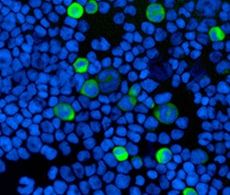
Fluorescence imaging Fluorescence imaging

Search
Search
EVOS™细胞成像系统可在保证性能的前提下,降低多色荧光成像的复杂程度。这一产品将数字倒置显微工作站的所有功能特性整合到一个紧凑设备中,可在数分钟内学会并熟练使用。即便是完全陌生的用户能够不必花太多时间学会分析数据,不必为显微镜操作担心。无论您需要获得出版级的精细图像,还是要计数细胞以便测定活力,这一类系统均可助您更轻松、智能、快速地完成任务。
Thermo Fisher Scientific针对您的应用提供了荧光成像解决方案 – 您可以根据自己的成像应用需要选择最合适的系统。以下任一内容都可能影响到您的平台选择:
请使用以下选择指南查找适合您的系统。
![]() EVOS FLoid 最适合快速荧光成像 | ![]() EVOS FL 最适合多通道荧光成像和转染 | ![]() EVOS FL Auto 2 最适合各类先进的自动化应用 | |
| 高分辨率LCD显示器 | 15" | 15" | 23" |
|---|---|---|---|
| 可选的物镜 | 20x固定 | 1.25x–100x | 1.25x–100x |
| 荧光通道 | 3(固定) | 4(可更换)* | 4(可更换)* |
| 照相机 | 黑白CCD | 可选择彩色或黑白CCD | 双色黑白(CCD)和彩色(CMOS) |
| 透射光(明场和相差成像) | ✓ | ✓ | ✓ |
| 荧光显微镜成像 | ✓ | ✓ | ✓ |
| 荧光通道 | 3 (DAPI, GFP, Texas Red) | 4 (可更换光立方) | 4 (可更换光立方) |
| 适合组织培养超净台 | ✓ | ||
| 延时成像 | ✓ | ✓ | |
| 桌面培养箱 | ✓ (optional) | ||
| 自动聚焦 | ✓ | ||
| 高分辨率成像拼接 | ✓ | ||
| 细胞计数 | ✓ | ✓ | |
| 重量 | 11.8 kg (26.0 lb) | 15.3 kg (33.7 lb) | 16 kg (35 lb) |
| 尺寸 | H: 53.6 cm (21.1") W: 40.4 cm (15.9") D: 35.3 cm (13.9") | H: 57.8 cm (22.8") W: 35.5 cm (14.0") D: 47.0 cm (18.5") | H: 36 cm (13") W: 33 cm (14") D: 46 cm (18") |
新细胞分析支持中心
查找可用于您的细胞分析工作流程的提示、疑难解答帮助及资源。
仅供科研使用,不可用于诊断目的。